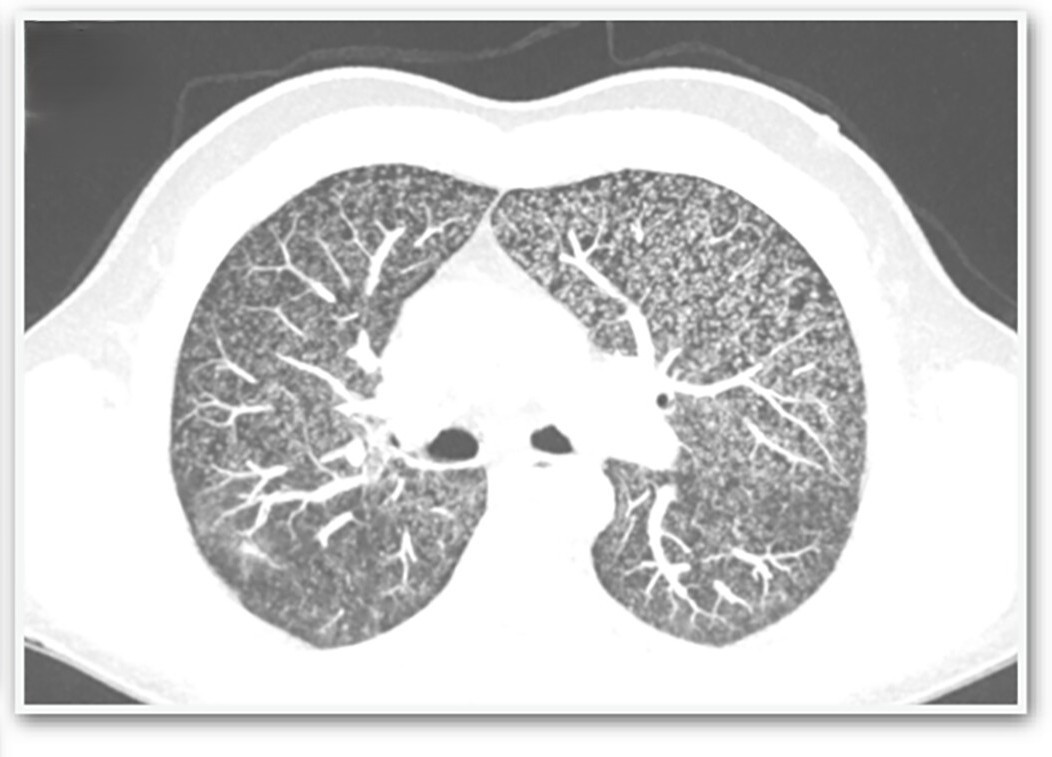

Robô humanoide super-realista tem mãos com força semelhante à humana; vídeo
[
](
)
Posted into Revista Galileu [@revista-galileu-RevistaGalileu](
)

Galileu
Mãos de robô super-realista têm força semelhante à humana; veja vídeo
Protótipo é caracterizado como uma rede de microfibras e treinada a partir de filmagens de mãos humanas em movimento. Assista

Galileu
Mãos de robô super-realista têm força semelhante à humana; veja vídeo
Protótipo é caracterizado como uma rede de microfibras e treinada a partir de filmagens de mãos humanas em movimento. Assista

Flipboard
Revista Galileu | @RevistaGalileu | Flipboard
A ciência ajuda você a mudar o mundo